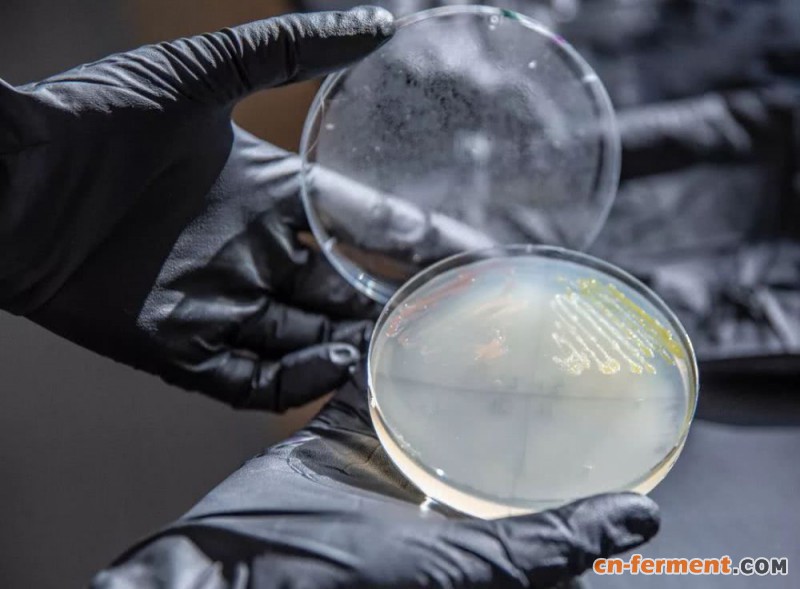
2
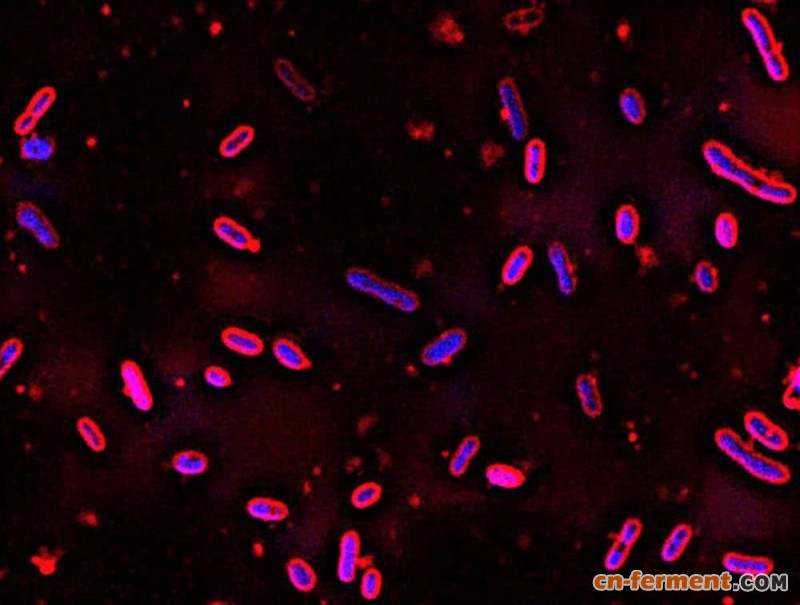
4

博科园-科学科普:这就留下了很多有用的纤维素,但也留下了很多木质素,而木质素从来没有多少价值。一个多世纪以来,造纸厂一直在从木材中提取木质素来造纸,但发现木质素的价值微乎其微,只能在造纸厂的锅炉里燃烧。威斯康辛大学麦迪逊分校土木与环境工程学研究生米格尔?佩雷斯表示:除了钱,木质素可以做任何事情。但是他们可能不像他那样了解诺沃斯芬哥宾芳香麝香猫。佩雷斯、土木和环境工程学教授丹尼尔·诺格拉(Daniel Noguera)以及GLBRC和威斯康辛能源研究所的同事们在《绿色化学》(Green Chemistry)期刊上发表了一篇论文。
威斯康辛大学麦迪逊分校博士后研究员亚历克斯·林兹(Alex Linz)研究了一个带有N.芳香果子兰(黄色)条纹的盘子。芳香果子兰是一种土壤细菌,可以将一种可再生资源(植物细胞中的木质素)转化为石油基塑料的替代品。图片:Chelsea Mamott, GLBRC
威斯康辛大学麦迪逊分校博士后研究员亚历克斯·林兹(Alex Linz)研究了一个带有N.芳香果子兰(黄色)条纹的盘子。芳香果子兰是一种土壤细菌,可以将一种可再生资源(植物细胞中的木质素)转化为石油基塑料的替代品。图片:Chelsea Mamott, GLBRC
研究如何利用N.芳香麝香树将木质素转化为更有价值的商品。Noguera说:木质素是地球上除石油外最丰富的芳香族化合物来源。但是,众所周知,这种巨大而复杂的木质素分子很难有效地分解成有用的组成部分。进入细菌,这是第一次分离,而蓬勃发展的土壤中富含芳香族化合物后,石油产品污染。在其他微生物挑挑拣拣的地方,芳香麝香是木质素中芳烃的生物漏斗。它的独特之处在于,它可以将几乎所有不同木质素分解成更小的芳香烃。以前尝试过的其他微生物可能能够消化木质素中发现的几种芳香化合物,当遇到这种微生物时,它已经能够很好地降解多种化合物。这使得这种微生物非常有前途。

在它的消化过程中,微生物将这些芳香化合物转化为2-吡咯-4,6-二羧酸——更易于管理的名称是PDC。通过从微生物中去除三个基因,研究人员把中间的PDC变成了这条线的末端。这些工程菌变成了一个漏斗,不同的木质素进入其中,PDC从其中流出。日本生物工程师已经使用PDC制造出各种各样的材料,这些材料将对消费品有用。研究发现这种化合物的性能与PET聚合物中最常见石油基添加剂相同,甚至更好。PET聚合物包括塑料瓶和合成纤维,是目前世界上生产最常见的聚合物。这将是一种很有吸引力的塑料替代品(在环境中自然分解,而且不会将类似激素的化合物渗入水中)只要PDC更容易获得。
显微镜下的N.芳香果子狸,最初是从被石油产品污染的土壤中分离出来的,当它遇到GLBRC的科学家时,已经有了一个有益的食欲。他们对微生物的基因改造可能会启动可再生塑料产业。图片:GLBRC
显微镜下的N.芳香果子狸,最初是从被石油产品污染的土壤中分离出来的,当它遇到GLBRC的科学家时,已经有了一个有益的食欲。他们对微生物的基因改造可能会启动可再生塑料产业。图片:GLBRC
这是没有工业流程可以做到这一点,因为现有的路线很难实现PDC。但是如果我们从纤维素中制造生物燃料,生产木质素(过去经常燃烧的东西)可以有效地将木质素转化为PDC,这可能会改变这种化合物的工业应用市场。目前,芳香果子狸的基因工程变异可以将木质素中至少59%的潜在有用化合物转化为PDC。但是这项新的研究显示出更大的潜力,而且佩雷斯有进一步控制微生物的目标。如果能让这条管道以足够的速度、足够的产量生产,就可能创造一个新的产业。

博科园-科学科普|研究/来自: 威斯康星大学麦迪逊分校/Chris Barncard





















































